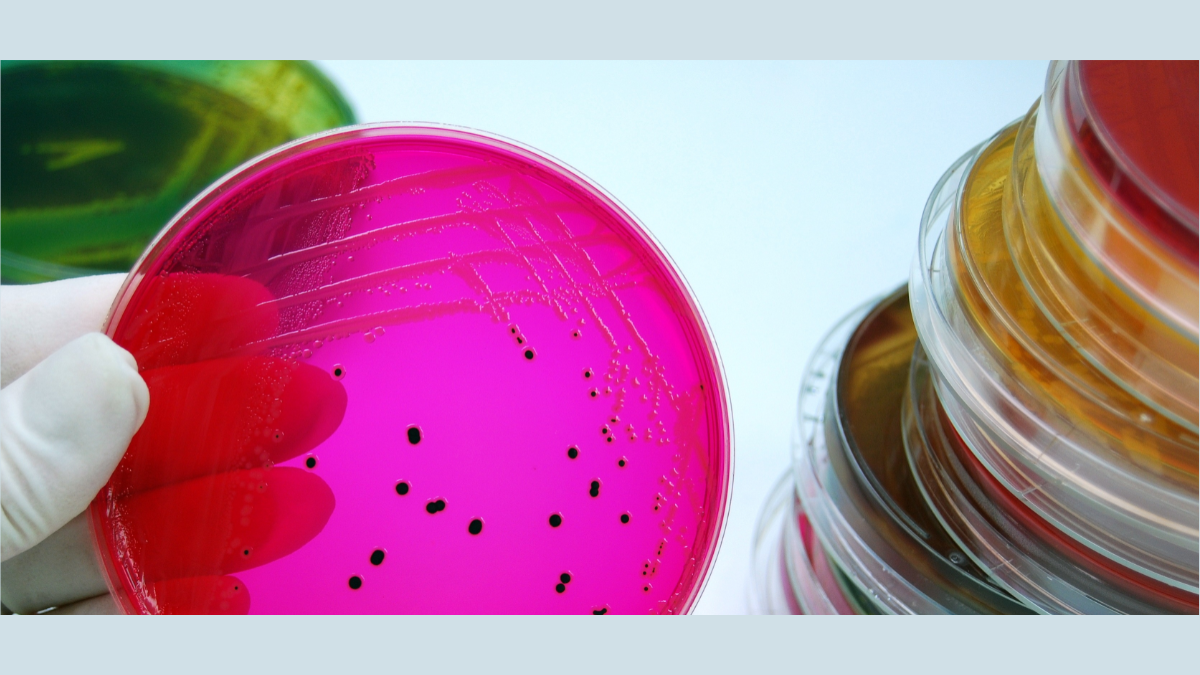
Image of Salmonella on petri dish, Getty Images

Weather change linked to increased risk of Salmonella outbreaks
Climate change is impacting the spread of Salmonella, according to new research from the University of Surrey. This research follows previous work from the team, which found that weather change is leading to the spread of dangerous diarrheal illness.
The study, led by a team of researchers at Surrey’s School of Veterinary Medicine, investigated the impact of different weather factors on the transmission of Salmonella - a leading cause of foodborne illnesses in Europe, accounting for nearly one in three foodborne outbreaks.
Salmonella is a type of bacteria that can cause food poisoning. It’s found in the intestines of animals and humans and can contaminate food if it’s not cooked or handled properly. Salmonella can cause diarrhoea, fever, and stomach cramps, and it is most prominent in areas with poor sanitation and hygiene.
In the study, published in the Journal of Infection, researchers compared UK Health Security Agency (UKHSA) data of confirmed cases of Salmonella in England and Wales during 2000-2016 with Met Office data of the time, focusing on 14 different weather factors. This provided a more holistic understanding, which considered the combined effect of multiple weather factors on incidences of Salmonella, leading to an in-depth description of the risk of salmonellosis when we know the local weather during the past days.
Warmer temperatures (above 10 degrees Celsius), relative humidity, dewpoint temperature (between 7-10 degrees Celsius), and longer days (over 12-15 hours) were identified as key weather factors associated with an increase in Salmonella cases, irrespective of geographical location. These findings were also validated by analysing data from the Netherlands.
The study highlights how weather plays a significant role in Salmonella outbreaks and provides a valuable tool for predicting future risks and tailoring interventions, particularly in the context of climate change.Dr Laura Gonzalez Villeta, first author of the study and researcher at the University of Surrey
Related sustainable development goals
Media Contacts
External Communications and PR team
Phone: +44 (0)1483 684380 / 688914 / 684378
Email: mediarelations@surrey.ac.uk
Out of hours: +44 (0)7773 479911